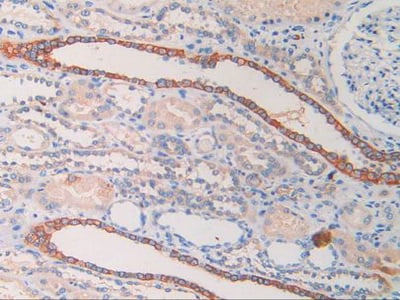
product-image-AAA147876_IHC8.jpg

Cytokeratin Fragment Antigen 21-1 Recombinant Protein | CYFRA21-1 recombinant protein
Recombinant Human Cytokeratin Fragment Antigen 21-1 (CYFRA21-1) Protein
Purity
> 90 % as determined by SDS-PAGE.
Synonyms
Cytokeratin Fragment Antigen 21-1; N/A; Recombinant Human Cytokeratin Fragment Antigen 21-1 (CYFRA21-1) Protein; K1C19_HUMAN; Keratin,typeIcytoskeletal19; Cytokeratin-19; CK-19; Keratin-19; K19; CYFRA21-1 recombinant protein
Host
E Coli
Purity/Purification
> 90 % as determined by SDS-PAGE.
Form/Format
Supplied as a 0.2 um filtered solution of 20mM Tris-Hcl, 15% Trehalose, 50 mM NaCl, 2mM EDTA, 10% Glycerol, 0.05% Tween80, pH 8.0
Concentration
2.14 mg/mL (varies by lot)
Sequence Positions
1-400
Sequence
MTSYSYRQSSATSSFGGLGGGSVRFGPGVAFRAPSIHGGSGGRGVSVSSARFVSSSSSGGYGGGYGGVLTASDGLLAGNEKLTMQNLNDRLASYLDKVRALEAANGELEVKIRDWYQKQGPGPSRDYSHYYTTIQDLRDKILGATIENSRIVLQIDNARLAADDFRTKFETEQALRMSVEADINGLRRVLDELTLARTDLEMQIEGLKEELAYLKKNHEEEISTLRGQVGGQVSVEVDSAPGTDLAKILSDMRSQYEVMAEQNRKDAEAWFTSRTEELNREVAGHTEQLQMSRSEVTDLRRTLQGLEIELQSQLSMKAALEDTLAETEARFGAQLAHIQALISGIEAQLGDVRADSERQNQEYQRLMDIKSRLEQEIATYRSLLEGQEDHYNNLSASKVL
Source
Human
Tag Information
with 6*His tagged.
Protein Residues
With N-Terminal 6*His tagged
Usage
CYFRA21-1 Protein - We recommend that this vial be briefly centrifuged prior to opening to bring the contents to the bottom. Please reconstitute protein in deionized sterile water to a concentration of 0.1-1 mg/mL. We recommend to add 5-50% of glycerol (final concentration) and aliquot for long-term storage at -20°C/-80°C. Our default final concentration of glycerol is 50%. Customers could use it as reference.
Preparation and Storage
Store it under sterile conditions at -20°C upon receiving. Recommend to aliquot the protein into smaller quantities for optimal storage. **Avoid repeated freeze-thaw cycles.** The recombinant protein is stable for long term from date of receipt at -20°C / -80°C.
Related Product Information for CYFRA21-1 recombinant protein
Cytokeratin19 Fragment Antigen 21-1(CYFRA21-1) belongs to a family of 20 related polypeptides that are constituents of the intermediate filaments of epithelial cells. Of these CK19 is the most frequently expressed cytokeratin endometrial cancer.
CYFRA21-1 is a common tumor marker of lung cancer,non-small-cell cancer, small cell carcinoma and squamous cell carcinoma. For breast cancer, CYFRA21-1 may be comparable to the sensitivity and specificity of CA153. Measured jointly with any of the tumor markers as CEA, SCCA, NSE, can increase the sensitivity. Other as bladder cancer, nasopharyngeal cancer, ovarian cancer, gastrointestinal cancer, and also have certain positive rate. CYFRA21-1 in hepatitis, pancreatitis, pneumonia, benign prostatic hyperplasia may also be increased.
CYFRA21-1 is a common tumor marker of lung cancer,non-small-cell cancer, small cell carcinoma and squamous cell carcinoma. For breast cancer, CYFRA21-1 may be comparable to the sensitivity and specificity of CA153. Measured jointly with any of the tumor markers as CEA, SCCA, NSE, can increase the sensitivity. Other as bladder cancer, nasopharyngeal cancer, ovarian cancer, gastrointestinal cancer, and also have certain positive rate. CYFRA21-1 in hepatitis, pancreatitis, pneumonia, benign prostatic hyperplasia may also be increased.
NCBI and Uniprot Product Information
UniProt Accession #
Molecular Weight
Predicted MW: 46.3 kDa
Observed MW: 40-50 kDa
Observed MW: 40-50 kDa
Customer Reviews
Loading reviews...
Share Your Experience
Similar Products
Product Notes
The CYFRA21-1 (Catalog #AAA55765) is a Recombinant Protein produced from E Coli and is intended for research purposes only. The product is available for immediate purchase. The immunogen sequence is 1-400 with tag with 6*His tagged. The amino acid sequence is listed below: MTSYSYRQSS ATSSFGGLGG GSVRFGPGVA FRAPSIHGGS GGRGVSVSSA RFVSSSSSGG YGGGYGGVLT ASDGLLAGNE KLTMQNLNDR LASYLDKVRA LEAANGELEV KIRDWYQKQG PGPSRDYSHY YTTIQDLRDK ILGATIENSR IVLQIDNARL AADDFRTKFE TEQALRMSVE ADINGLRRVL DELTLARTDL EMQIEGLKEE LAYLKKNHEE EISTLRGQVG GQVSVEVDSA PGTDLAKILS DMRSQYEVMA EQNRKDAEAW FTSRTEELNR EVAGHTEQLQ MSRSEVTDLR RTLQGLEIEL QSQLSMKAAL EDTLAETEAR FGAQLAHIQA LISGIEAQLG DVRADSERQN QEYQRLMDIK SRLEQEIATY RSLLEGQEDH YNNLSASKVL. It is sometimes possible for the material contained within the vial of "Cytokeratin Fragment Antigen 21-1, Recombinant Protein" to become dispersed throughout the inside of the vial, particularly around the seal of said vial, during shipment and storage. We always suggest centrifuging these vials to consolidate all of the liquid away from the lid and to the bottom of the vial prior to opening. Please be advised that certain products may require dry ice for shipping and that, if this is the case, an additional dry ice fee may also be required.Precautions
All products in the AAA Biotech catalog are strictly for research-use only, and are absolutely not suitable for use in any sort of medical, therapeutic, prophylactic, in-vivo, or diagnostic capacity. By purchasing a product from AAA Biotech, you are explicitly certifying that said products will be properly tested and used in line with industry standard. AAA Biotech and its authorized distribution partners reserve the right to refuse to fulfill any order if we have any indication that a purchaser may be intending to use a product outside of our accepted criteria.Disclaimer
Though we do strive to guarantee the information represented in this datasheet, AAA Biotech cannot be held responsible for any oversights or imprecisions. AAA Biotech reserves the right to adjust any aspect of this datasheet at any time and without notice. It is the responsibility of the customer to inform AAA Biotech of any product performance issues observed or experienced within 30 days of receipt of said product. To see additional details on this or any of our other policies, please see our Terms & Conditions page.Item has been added to Shopping Cart
If you are ready to order, navigate to Shopping Cart and get ready to checkout.